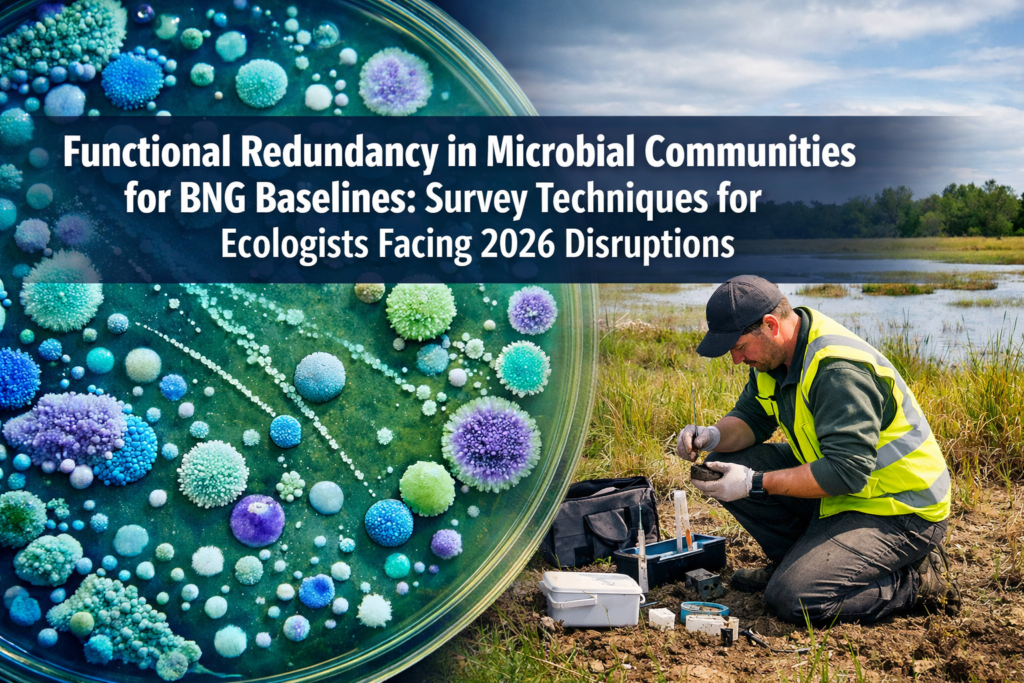
Functional Redundancy in Microbial Communities for BNG Baselines: Survey Techniques for Ecologists Facing 2026 Disruptions

Citizen Science Integration in Biodiversity Net Gain Surveys: Scalable Protocols for 2026 Community-Ecologist Partnerships

Nearly 100,000 priority ponds across the UK remain unrecorded—a staggering biodiversity data gap that professional ecologists alone cannot close. Yet in just two years, community volunteers have identified over 250 new priority ponds through structured citizen science programs, demonstrating that Citizen Science Integration in Biodiversity Net Gain Surveys: Scalable Protocols for 2026 Community-Ecologist Partnerships represents […]
Species Distribution Shifts in BNG Sites: Climate Velocity Mapping Protocols for Biodiversity Surveyors

Recent research reveals that observed species range shifts occur at rates approximately four times faster than climate niche models predicted—a finding that fundamentally challenges how biodiversity surveyors approach Biodiversity Net Gain (BNG) site management in 2026. When static baseline assessments meet dynamic ecological reality, the question becomes: how can professionals track and adapt to species […]
Functional Redundancy in Microbial Communities for BNG Baselines: Survey Techniques for Ecologists Facing 2026 Disruptions
Microbiomes in major estuarine systems demonstrate metabolic flexibility across more than 50 different energy pathways—yet this hidden functional insurance policy remains largely unmeasured in Biodiversity Net Gain (BNG) assessments[3]. As development projects accelerate across England in 2026, ecologists face mounting pressure to establish robust ecological baselines that account for invisible but critical microbial communities. Understanding […]
Alpine Ecosystem Surveys for High-Altitude BNG: Protocols Addressing 2026 Permafrost Thaw and Treeline Shifts

Permafrost thaw is rewriting the biodiversity baseline across alpine regions at an unprecedented pace. Recent research reveals that over 2,000 treeline species records from 39 mountain regions now document systematic upslope migration, while ground-penetrating radar surveys detect active layer deepening that fundamentally alters habitat structure [1]. For developers and land managers implementing Alpine Ecosystem Surveys […]
Ocean Acidification Impacts on BNG Marine Surveys: Protocols for Shellfish and Coral Habitat Assessments in 2026

Ocean acidity has increased 26% over the past 250 years, with pH dropping from a global average of 8.2 to 8.1[1]. This seemingly minor shift represents a chemical transformation occurring at approximately 10 times faster than any point in the last 300 million years[2]. For marine surveyors conducting Biodiversity Net Gain (BNG) assessments in 2026, […]


